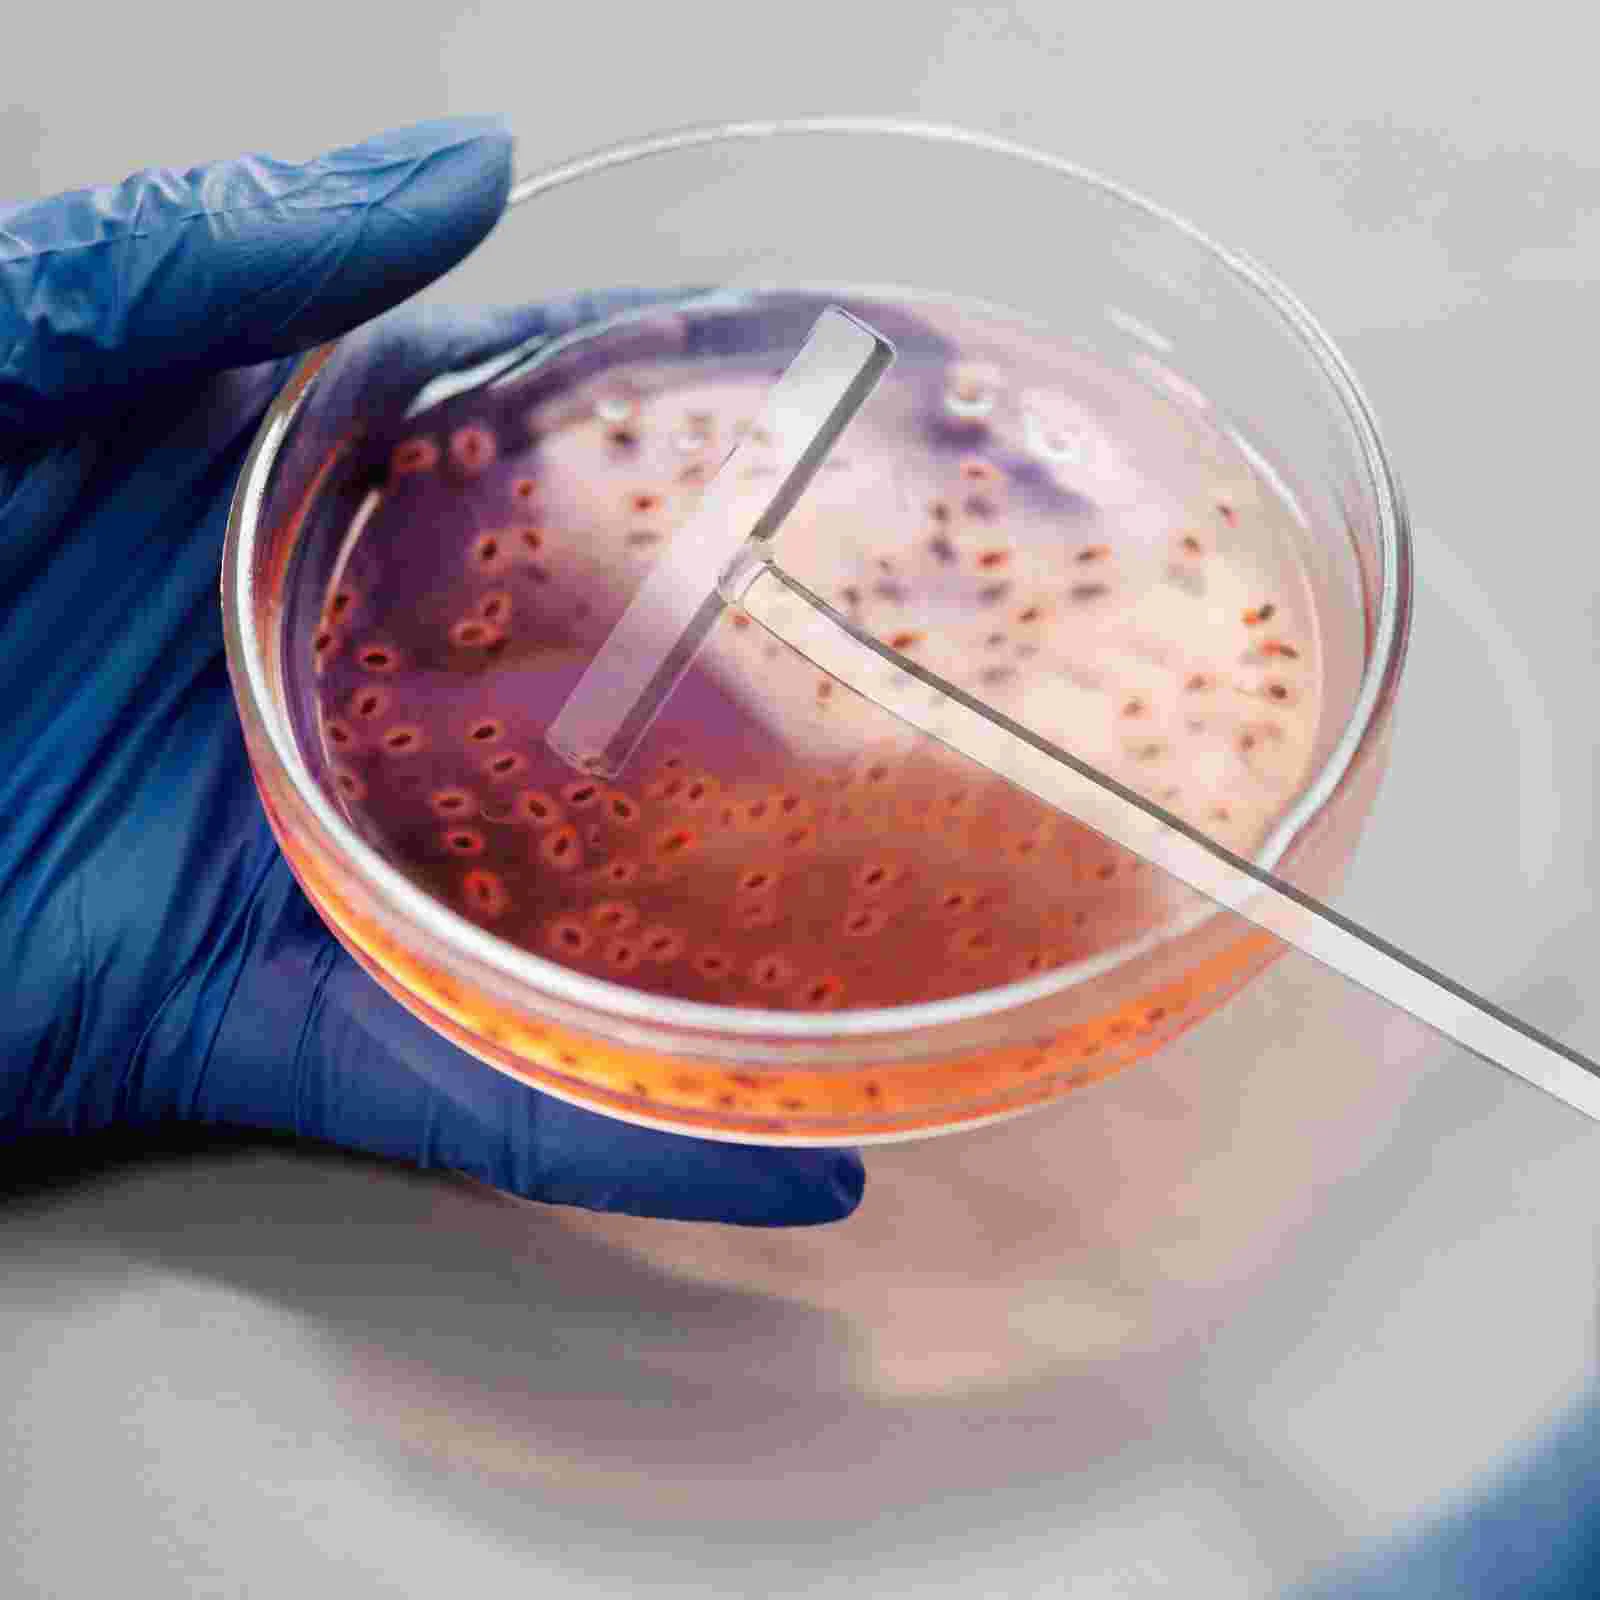

3 шт. разбрасыватель ячеек для размазывания 1870X400X150CM стекло лабораторный инструмент оборудование
Price history chart & currency exchange rate
Customers also viewed

$12.98
1pcs Cat Stripe Spoon Feeder, Cat Feeding Spoon, Cat Stripe Squeezing Food Snack Spoon, Pet Tableware помаранчевий
joom.com
$53.17
European and American Large Capacity Tote Bags Handbags High End Touching Work Bags High Quality Fashion Underarm Shoulder Bags
joom.com
$109.47
Fossil Men Fossil Blue Dive Stainless Steel Straps Reset Time Analogue Watch FS6035, Gold
myntra.com
$2.06
1 Pcs Oven Knob Stainless Steel Pot Pan Lid Cover Handle Replacement Accessories Kits Kitchen Cookware Hardware
aliexpress.ru
$37.46
Передняя навес на крышу для BMW X1 E84 2009-2014 54102993888, автомобильные панорамные навес на крышу, навес на крышу, раздвижные комплекты
aliexpress.ru
$16.21
Женский комплект вязаной мини-юбки Y2K без рукавов, ажурный топ в рубчик, облегающая мини-юбка, эстетическое платье, Пляжная накидка
aliexpress.ru
$16.13
Фонарь с датчиком движения, фонарь с подсветкой, беспроводной USB Перезаряжаемый кухонный ночник
aliexpress.ru
$11.04
Лидер продаж, летний комплект из футболки и брюк, повседневные брендовые штаны для фитнеса и бега, футболка, модный мужской спортивный костю...
aliexpress.ru
$7.37
Боковой зеркальный фонарь, динамический поворотный сигнал, фонарь последовательно для Toyota Alphard Vellfire AH30 Tacoma 16-19 RAV4 2019 -20 Highlander 2020
aliexpress.ru
$3.53
Прочный черный тактический ремень с быстроразъемной пряжкой для безопасности и выживания
aliexpress.ru
$628.00
Dc 96v Solar Charge Controller Mppt 100a Solar Charge Controller For Solar Power System
aliexpress.com
$1.14
10 pieces/lot 5*30mm Brush Pen Charm Pendant Bracelet Key chain Antique silver color Metal DIY handmade jewelry making
aliexpress.com
$15.79
for Yamaha Drive (G29) Golf Cart Throttle Sensor JW2-H5885-00 Accelerator Position Sensor Golf Cart Accessories
aliexpress.com
$115.72
Использованная ILLIT I LL LIKE YOU WONHEE GS25 LUCKY DRAW Фотокарта Резервирование Benefit Limited POB
joom.ru
$186.16
cow leather tiger bags 34cm as 101311 new fashion women totes messenger crossbody purse travel shoulder handbag
dhgate.com
$11.50
3-полосный EQ преамп цепи гитары двойной потенциометр для активного бас-гитары звукосниматель 5 ручек управления управление звукоснимателем...
aliexpress.ru
$51.86
men's pants spring fashion dmek cashew blossom stitched guard pants thin loose straight leg drawstring terry, Black
dhgate.com
$22.86
swedish fox outdoor bags classic backpack fashion style design bag junior fjallravan canvas waterproof fashion sports kanken
dhgate.com
$72.74
shop jewelry discounts new brass rhinestone letter pearl earrings five pointed star heart earrings female, Golden
dhgate.com
$76.16
Стеллаж 100x130x50 см, Харди-Про, Белый, 3 полки ДСП, до 120 кг/полку (Харди-Про-15810, металлический, модульный, полочный, разборной для дома, офиса, кладовки, гаража, магазина, склада)/Стелаж металевий для дому, офісу, комори, складу
rozetka.com.ua
$19.22
Креативная современная металлическая модель в виде листьев, художественное ремесло, украшение для дома, гостиной, ТВ, кабинета, декоративны...
aliexpress.com
$25.00
10 шт./лот 18 Вт PD зарядный кабель USB кабель передачи данных Тип C для iPhone 11 Pro XS Max 8 Plus быстрое зарядное устройство для осветительных кабелей 1 м 2 ...
aliexpress.ru
$12.03
Metal Car Rear Tail Fog Light Lamp Cover Decoration Trim for Jeep Renegade 2015 Up Exterior Accessories Car Styling Silver
aliexpress.com